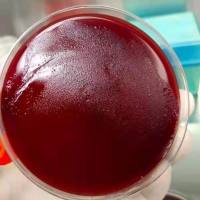
幽门螺旋杆菌

万千商家帮你免费找货
0 人在求购买到急需产品
- 详细信息
- 文献和实验
- 技术资料
- 英文名:
Cystobacter fuscus
- 保质期:
20年
- 供应商:
智立中特(武汉)生物科技有限公司
- 保存条件:
2-8度
- 规格:
冻干粉
Name:
Cystobacter fuscus Schroeter 1886
DSM No.:
2262, Type strain
Strain designation:
M29
Other collection no.
or WDCM no.:
ATCC 25194,NBRC 100088
Isolated from:
soil
Country:
Canada
Date of sampling:
before 19.01.1982
Nagoya Protocol Restrictions:
There are NO known Nagoya Protocol restrictions for this strain.
History:
<- ATCC <- H.D. McCurdy, M29 (Polyangium fuscum)
Genbank accession numbers:
16S rRNA gene: KP306730
16S rRNA gene: DQ768109
whole genome shotgun sequence: ANAH00000000
Cultivation conditions:
Medium 222 , 30°C
or
Medium 9 , 30°C
风险提示:丁香通仅作为第三方平台,为商家信息发布提供平台空间。用户咨询产品时请注意保护个人信息及财产安全,合理判断,谨慎选购商品,商家和用户对交易行为负责。对于医疗器械类产品,请先查证核实企业经营资质和医疗器械产品注册证情况。
文献和实验Name:
Cystobacter fuscus Schroeter 1886
DSM No.:
2262, Type strain
Strain designation:
M29
Other collection no.
or WDCM no.:
ATCC 25194,NBRC 100088
Isolated from:
soil
Country:
Canada
Date of sampling:
before 19.01.1982
Nagoya Protocol Restrictions:
There are NO known Nagoya Protocol restrictions for this strain.
History:
<- ATCC <- H.D. McCurdy, M29 (Polyangium fuscum)
Genbank accession numbers:
16S rRNA gene: KP306730
16S rRNA gene: DQ768109
whole genome shotgun sequence: ANAH00000000
Cultivation conditions:
Medium 222 , 30°C
or
Medium 9 , 30°C
技术资料暂无技术资料 索取技术资料